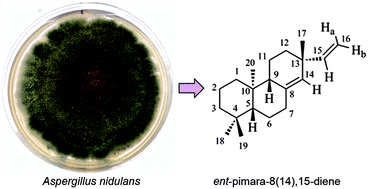

We recently engineered Aspergillus nidulans to produce a pimarane-type diterpene, ent-pimara-8(14),15-diene. Here, we describe methods for its isolation and purification from the engineered A. nidulans production strain and extend these findings with structural confirmation for the diterpene from this fungal source. The extraction protocol was optimized using accelerated solvent extraction (ASE) with three varying parameters: solvent composition, pressure, and temperature. This ASE method using 100% ethyl acetate at 90 °C with 12.07 MPa was more efficient and faster compared to ultrasonic-assisted extraction. Using both analytical and preparative C18 columns at isocratic elution of acetonitrile developed an HPLC separation; and, the diterpene was well separated within 28 min and 35 min, respectively. Also, TLC of the fungal culture extracts was performed with visualization using rhodamine. The reproduction and efficiency of the purification methods were evaluated by GC-MS; and, the structure of the compound was verified by NMR. The method enabled the isolation of this very lipophilic diterpene in pure form, allowing its testing in a number of bioactivity assays. Notably, we demonstrate for the first time the antioxidant activity for ent-pimara-8(14),15-diene using the 2,2-diphenyl-1-picrylhydrazyl (DPPH) assay.